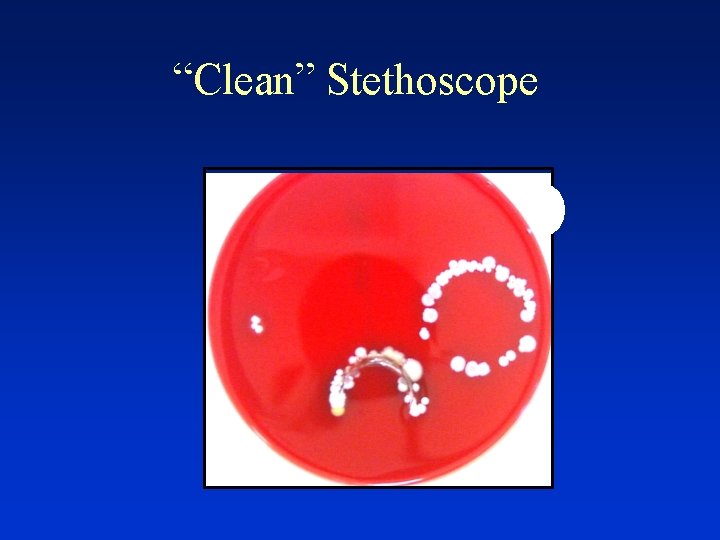
“Clean” Stethoscope

Infection Control Introduction to Infection Control Carol Sulis

- Slides: 45
Infection Control
Introduction to Infection Control Carol Sulis, MD Associate Professor of Medicine Boston University School of Medicine Hospital Epidemiologist Boston Medical Center
HOSPITAL EPIDEMIOLOGY Identification Prevention and Control Of Hospital Acquired Infections
UNDERSTAND METHODS TO: • Prevent exposure from bloodborne pathogens • Prevent exposure from TB • Implement the BMC isolation system • Reduce risk of infection among patients and staff HOT TOPICS • Patient Safety • Abx resistance • BT readiness • The “next” pandemic IMPACT OF NOSOCOMIAL INFECTIONS • 2 -4 million patients/year affected. • Hospital stay increased > 30% • Increased risk of secondary spread • Increased risk of death • Estimated annual cost ~ $5 billion
Standard Isolation Precautions Used to perform any task or procedure which could result in the contamination of skin, mucous membranes, or clothing with blood, body fluids, secretions, excretions (except sweat), or other potentially infectious material, regardless of whether or not they contain visible blood • • Hand Hygiene Eye and Face Protection Use of gowns and gloves Sharps management
"Hi, we are the germs. We may look friendly, but do not be fooled, we can make you ill. To make us disappear, wash your hands correctly. " HAND SANITATION: • ANTIBACTERIAL SOAP & WATER • WATERLESS HAND DISINFECTANT- Cal-Stat
STANDARD ISOLATION PRECAUTIONS For Contact With All Blood and Body Fluids Hand Sanitation Mask & Eye Protection Glove Use Gown if Contamination is Likely
• Anticipate the potential for exposure • Don appropriate PPE • Disinfect and/or remove after use
• Discard DISPOSABLES in Appropriate Waste Receptacle • Disinfect and/or Sterilize REUSABLES – Affix biohazard label if contaminated – Clean/decontaminate prior to disinfection or sterilization – Use appropriate chemical and method (LLD, HLD, steam) • Disinfect SPILLS with approved germicide wipe – 2 minutes for Oxivir (purple top – 4 minutes with Bleach (orange top) • Disinfect SHARED EQUIPMENT between patients (PDI Wipes)
RISK OF INFECTION AFTER OCCUPATIONAL EXPOSURE • HEPATITIS B • 6 -30 % • HEPATITIS C • 2 -6 % • HIV • <1%
DO’S AND DON’TS
• NEEDLESTICK / PUNCTURE WOUND • MUCOUS MEMBRANE • OPEN WOUND CONTACT WITH BLOOD OR OPIM
Percutaneous Exposures at BMC: 2018 n = 142
• First Aid • Notify Supervisor • Get evaluated immediately – Go to OEM (DOB 7; Beep 3580) or ED if closed • Post-exposure prophylaxis within 1 hour DO NOT DELAY!
Transmission-Based Isolation • Use in addition to standard isolation for patients with known/suspected infection/colonization with highly transmissible or epidemiologically important pathogens • Three types – Contact (C), Contact-Plus (for C. difficile) – Droplet (D) – Airborne (A)
• TRANSMISSION BY DIRECT CONTACT • Multi-drug resistant infection/colonization: e. g. MRSA, VRE, CRE • Enteric infections such as: Salmonella, E. coli 0157: H 7 if patient incontinent
C. difficile Candida auris Norovirus
LARGE PARTICLE DROPLETS SPREAD WITHIN 3 FEET WEAR A MASK, GET VACCINATED! • • • Hemophilus influenzae type b Meningococcemia Pertussis Influenza Mumps, Rubella
• M. tuberculosis • Varicella • Measles
Measles = Rubeola
• • Identify patients with active TB early Initiate Airborne Precautions promptly Initiate effective anti-TB therapy promptly Use a properly fitted N 95 respirator for room entry or for cough inducing procedures • Get an annual TST
H 7 N 9, MERS-Co. V, SARI Screen for potential exposures (travel to affected areas, contact with ill persons or dead or dying poultry from affected areas, work in lab that processes viral specimens) Use contact, droplet, airborne isolation, plus goggles Precaution type: ENHANCED Call ID Fellow or IP Nurse 8/11/17 New York Times, 2003
Special Problems • Facility design, construction, renovation, maintenance
What is your role in reducing the risk for patients?
12 Steps to Prevent Antimicrobial Resistance: Hospitalized Adults Clinicians hold the solution… Take steps NOW to prevent antimicrobial resistance! 12 Contain your contagion Prevent Transmission 11 Isolate the pathogen 10 Stop treatment when cured 9 Know when to say “no” to vanco 8 Treat infection, not colonization Use Antimicrobials Wisely 7 Treat infection, not contamination 6 Access the experts 5 Use local data 4 Practice antimicrobial control Diagnose & Treat Effectively 3 Target the pathogen 2 Get the catheters out Prevent Infections 1 Vaccinate
Hand Wash Campaign Getting From “I Know” to “I Do”
“Yes, My hands are clean…”
Hand after Soap & Water Wash
Hand after Cal. Stat Rub
After Soap & Water Wash Hand With Acrylic Nails
“Clean” Stethoscope
Stethoscope After Alcohol Wipe
Focus on Hand Hygiene • each patient contact, hands must be “sanitized” with alcohol hand rub or antimicrobial soap • JCAHO focus area since 2004 • Each Department must monitor compliance
Ongoing. . Copyright (c) 1997 -2008 Rakuten, Inc.
Hand Hygiene in ICU: 2015
Prevention of Healthcare Associated Infections Save 100, 000 Lives Campaign • • • Foley Catheter Associated UTI (CAUTI) C. difficile associated diarrhea (CDAD) CVC Associated BSI (CLABSI) Surgical Site Infections (SSI) Ventilator Associated Pneumonia (VAP) Hand Hygiene